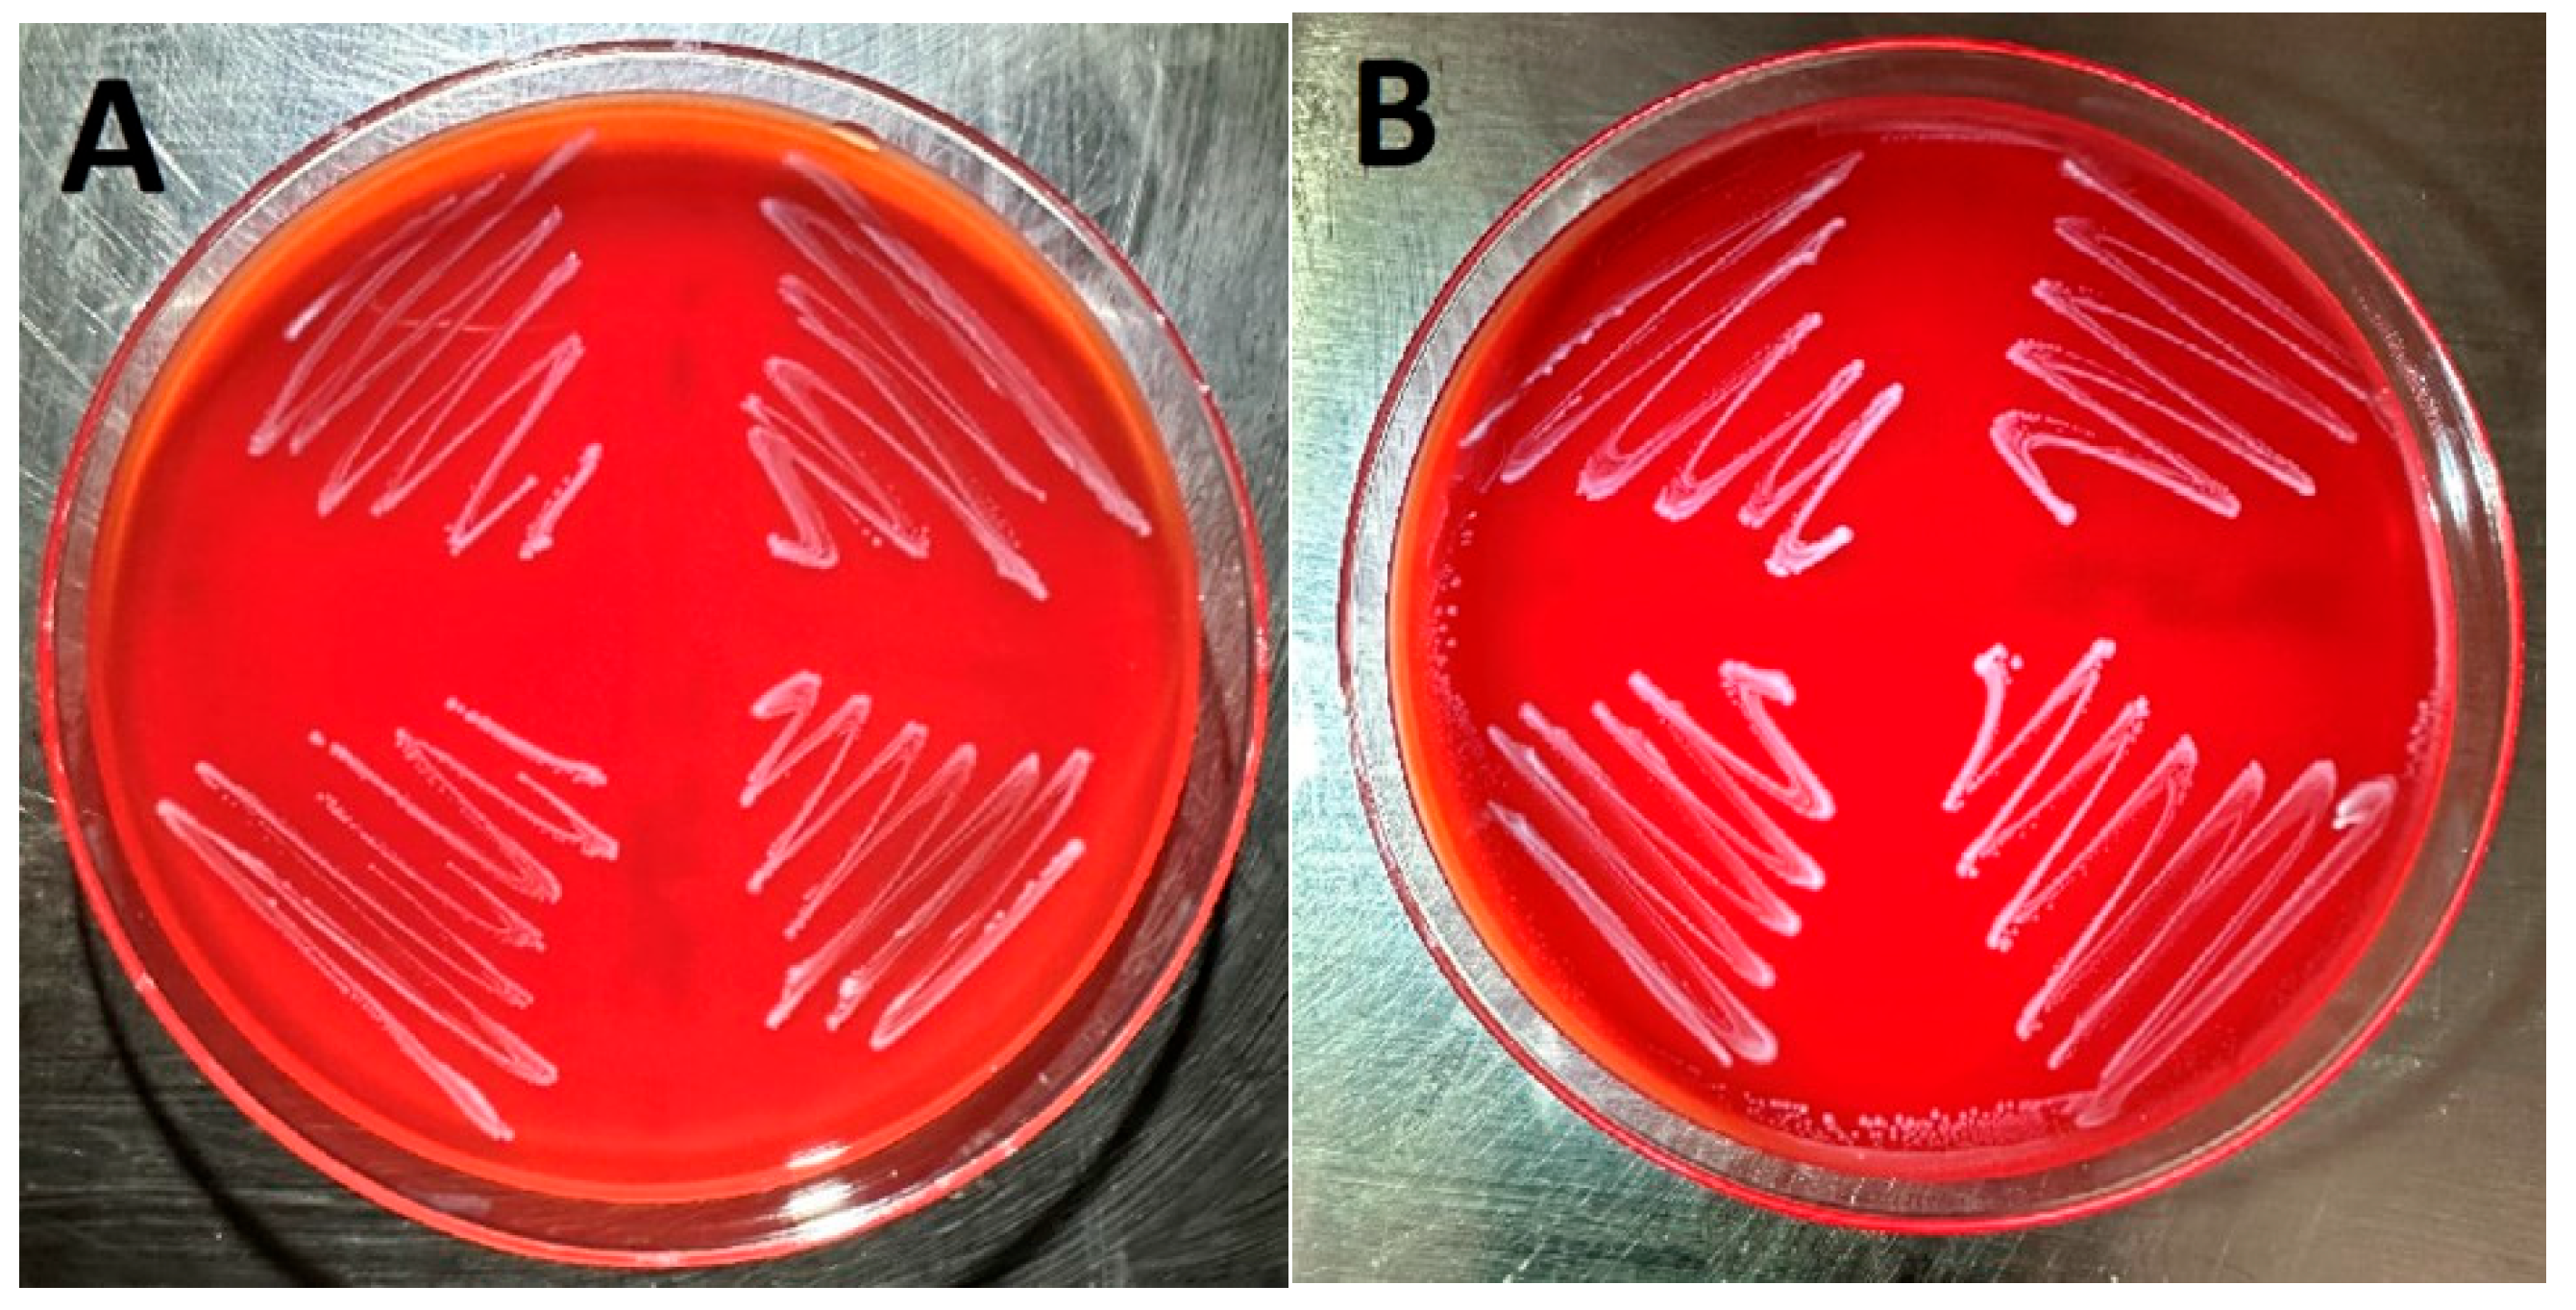
Poultry 04 00011 g001

Abstract
Enterococcus faecalis (E. faecalis) is a ubiquitous microbe occurring in the environment and in the intestinal tract of poultry. E. faecalis has been identified in cases of egg infertility and/or decreased hatchability and can cause amyloid arthropathy in older laying chickens. E. faecalis produces cytolysin, a bacterial exotoxin that can cause lysis of erythrocytes. It has been difficult to demonstrate this virulence trait using conventional culture methods with sheep blood agar. A 96-well microplate hemolysis assay, along with a culture method incorporating glucose and L-arginine into the culture media, is described that demonstrates the production of cytolysin in E. faecalis isolates of avian origin. Additionally, the results show that horse and sheep erythrocytes were susceptible to lysis by the E. faecalis cytolysin, but cow and chicken erythrocytes were less susceptible.
1. Introduction
The Enterococcus species are Gram-positive bacteria that are omnipresent, occurring in soil, water and as a component of the intestinal microbiota of many animal species [1]. Enterococcus faecalis (E. faecalis) is a ubiquitous microbe occurring in the environment and in the intestinal tract of poultry [2]. E. faecalis is often isolated from hatching eggs and the hatchery environment, where it may cause embryo mortality and can rapidly spread to hatchlings. E. faecalis is vertically transmitted either on or through the egg and may be responsible for egg infertility and/or decreased hatchability [3,4,5,6]. E. faecalis can cause amyloid arthropathy in older laying chickens [7,8,9]. E. faecalis has numerous virulence traits including antimicrobial resistance genes which can be transferrable to other bacteria, biofilm formation, and the exotoxin cytolysin/hemolysin [10,11,12,13]. Cytolysin, often referred to as hemolysin (and streptolysin in the early literature) [1,11,14], is active against both prokaryotic and eukaryotic cells [10,11,14]. It is a pore-forming exotoxin that lyses cells and responds to quorum signals [14,15]. As a bacteriocin, cytolysin aids bacteria in establishing colonization by impeding the growth of competing Gram-positive bacteria [1]. Cytolysin also acts against eukaryotic cells, where it is toxigenic, and plays an important role in the severity of tissue damage and increased lethality [1,10,11]. The E. faecalis cytolysin is a complex molecule encoded by eight genes and expressed as two molecules, with the smaller molecule involved in quorum signaling [1,10,11,12,14,16]. Cytolysin can lyse erythrocytes although the susceptibility of erythrocytes to cytolysin varies substantially depending on the animal species from which the erythrocytes originate. It has been reported that hemolysis is observed when E. faecalis is cultured on agar prepared with either horse, human, dog, rabbit, or mouse erythrocytes but not with sheep, cow, or goose erythrocytes [14,17,18]. Maasjost et al., evaluated ten E. faecalis isolates originating from meat turkeys and were unable to demonstrate cytolysin-induced hemolysis using horse blood agar, even though the presence of cytolysin genes was established in seven of the isolates [19]. Stepien-Pysniak, et al., evaluated 76 E. faecalis isolates originating from broiler chicks with yolk sac infections but were unable to demonstrate hemolysis in any of the isolates using horse blood agar [20]. Here, we report a reliable method for demonstrating E. faecalis cytolysin using a microplate hemolysis assay.
2. Materials and Methods
2.1. Ethical Statement
This study was conducted at the University of Nebraska–Lincoln. The protocols for animal blood collection were approved by the Institutional Animal Care and Use Committee (Project ID 2599, approved on 20 May 2024. This is a 3-year approval due to expire on 20 May 2027).
2.2. Erythrocytes
Horse, bovine and sheep erythrocytes were obtained from a commercial source (Hardy Diagnostics; Santa Maria, CA, USA) as defibrinated blood. Chicken erythrocytes were collected from a flock of specific pathogen-free layer-type chickens housed on-site in a biosafety level 2 containment facility. Specific pathogen-free eggs were obtained from VALO BioMedia North America LLC., (Adel, IA, USA). The eggs were hatched on site in a biosafety level 2 containment facility. Hatchlings were raised to adulthood in the same facility and used as blood donor birds. Blood was obtained using the brachial-vein method using heparin as the anticoagulant. Erythrocytes were washed three times in phosphate-buffered saline (PBS), then brought to a final volume of 1% in PBS, and the solutions were used within 2 h of preparation.
2.3. Enterococcus faecalis Isolates
The Nebraska Veterinary Diagnostic Center (NVDC) has a repository of E. faecalis field isolates from various avian species including chickens, turkeys and game birds. The isolates used, and their species of origin, are listed in Table 1. The E. faecalis isolates were streaked onto sheep blood agar and Columbia nalidixic acid agar (Thermo Fisher Scientific, Remel Products; Lenexa, KS, USA) plates and incubated for 48 h at 37 °C before being evaluated for beta-hemolysis. E. faecalis isolates were cultured overnight at 37 °C in either brain heart infusion (BHI) broth (BD; Franklin Lakes, NJ, USA) or BHI broth supplemented with 1% glucose (AmBeed, Inc.; Arlington Heights, IL, USA) and 0.03% L-arginine (AmBeed, Inc.; Arlington Heights, IL, USA; BHIGA) by inoculating 5 mL of the broth culture with an isolated E. faecalis colony selected from a sheep blood agar plate. Following overnight incubation, the cultures were centrifuged at 4000× g for 15 min. The supernatants were removed and filtered through a 0.22 µm filter. The filtrate was then used in the microplate hemolysis assay.
Table 1.
Hemolysis results of E. faecalis isolates of poultry origin using horse erythrocytes.
2.4. Microplate Hemolysis Assay
A 100 µL volume of the undiluted E. faecalis filtrate or 100 µL of 0.01% sodium dodecyl sulfate (SDS; Bio-Rad Laboratories, Hercules, CA, USA) in PBS (used as a positive control) was delivered to each well of a 96-well conical bottom microtiter plate. Additionally, 100 µL of PBS and BHIGA or BHI broth were delivered to wells as negative controls. This was followed by adding 100 µL of a 1% erythrocyte suspension in PBS to each of the wells. The plate was allowed to incubate for 1 h and then centrifuged at 3000× g for 10 min. Next, 100 µL of the supernatants were removed and transferred to a flat bottom 96-well microtiter plate and the optical densities (OD) were determined using a microplate reader set to 405 nm. The hemolysis assay was conducted at room temperature.
2.5. Experimental Design
Each E. faecalis isolate was evaluated for beta-hemolysis using sheep blood agar and Columbia nalidixic acid agar plates. The isolates were also evaluated for hemolysis using the microplate hemolysis assay utilizing horse erythrocytes and using eight wells (i.e., one OD reading per well) per isolate filtrate. Susceptibility of erythrocytes from four animal species to hemolysis was evaluated using erythrocytes from horse, chicken, sheep and cattle. The microplate hemolysis assay was employed using the filtrate from the E. faecalis isolate designated as sample number 1 (see Table 1). Eight individual well replicates (i.e., one OD reading per well) were performed for each erythrocytes species as well as for positive (i.e., SDS) and negative (PBS or BHIGA) controls. A hemolysis index was calculated for each E. faecalis isolate and for the animal species erythrocytes as follows:
2.6. Statistical Analysis
A Student’s t-test was used to compare the OD readings from the hemolysis of E. faecalis filtrates to those of its corresponding negative control (i.e., BHI or BHIGA media) and the SDS positive control to its corresponding negative control (i.e., PBS). A Student’s t-test along with the Bonferroni test was used to compare the susceptibilities of the erythrocytes from different species. Statistical significance was determined at an alpha of 0.001.
3. Results
Images of four E. faecalis isolates cultured on sheep blood agar (Figure 1A) and Columbia nalidixic acid agar (Figure 1B) are displayed in Figure 1. These isolates correspond to samples 1–4 in Table 1. As can be observed, no hemolysis was detected when the isolates were cultured on either sheep blood agar or Columbia nalidixic acid agar.
Figure 1.
Four E. faecalis isolates cultured on sheep blood agar (A) and Columbia nalidixic acid agar (B).
The results of the hemolysis microplate assay performed on E. faecalis sample 1 are displayed in Table 2. The data from the SDS positive control compared to its corresponding PBS negative control are significant (p < 0.001) as are the data from the E. faecalis sample 1 filtrate when compared to its corresponding control (BHIGA media, p < 0.001). The hemolysis results of 12 E. faecalis isolates originating from various species of poultry are displayed in Table 1. As can be observed, all isolates exhibited hemolysis when cultured in BHIGA broth, and their corresponding filtrates were used in the microplate hemolysis assay.
Table 2.
Hemolysis assay data using E. faecalis sample 1 and horse erythrocytes.
The hemolysis indices of an E. faecalis isolate (sample 1) cultured in BHI and in BHIGA broth are displayed in Figure 2, along with the SDS positive control.
Figure 2.
Hemolysis indices of E. faecalis isolate sample 1 grown in BHI vs. BHI media supplemented with glucose and arginine (BHIGA) when using horse erythrocytes.
The hemolysis indices of the E. faecalis sample 1 isolate, using erythrocytes originating from four different animal species, are displayed in Figure 3. The hemolysis results for 10 E. faecalis isolates using chicken and horse blood are displayed in Figure 4.
Figure 3.
Hemolysis indices of an E. faecalis isolate sample 1 grown in BHIGA media using erythrocytes from different animal species.
Figure 4.
The average hemolysis indices from 10 E. faecalis isolates using chicken and horse blood. Error bars represent standard deviations.
4. Discussion
Cytolysin produced by E. faecalis is a bacterial exotoxin capable of lysing erythrocytes and is an important virulence factor causing tissue damage and increasing lethality [1,10,11]. However, it is frequently the case that E. faecalis isolates do not exhibit beta-hemolysis in broth or blood agar cultures [16,19]. This was the case in this study as is clearly evidenced by Figure 1A,B, which demonstrate E. faecalis growth on both sheep blood agar and Columbia nalidixic acid agar without evidence of hemolysis.
A microplate hemolysis assay, previously described in [21], was modified for use in this study. The microplate hemolysis assay proved to be sensitive, allowed sample replication, and produced objective data that could be statistically analyzed. Table 2 shows an example of data obtained from the microplate hemolysis assay using an E. faecalis isolate (i.e., sample 1) and horse erythrocytes. Using eight replicates (i.e., wells) per isolate allowed for an average value with a low standard deviation and provided statistical significance (p < 0.001) when compared to corresponding negative controls. The numerical data also allowed the computation of a hemolysis index for each isolate that proved useful for demonstrating relative levels of hemolysis and making comparisons. By definition, the hemolysis index of the SDS positive control equals 100% and the hemolysis values of the corresponding filtrates included in the trial are compared to the SDS positive control. This approach allows for more consistent comparisons between trials where there may be slight differences in the number or age of the erythrocytes used. It should be noted that the hemolysis index for a given isolate varied when repeated. This was believed to be due to the amount of cytolysin contained in the filtrate being assayed. The variables that could influence the amount of cytolysin contained in a sample could be directly related to the number of E. faecalis organisms producing the toxin. This number could be influenced by the initial inoculum of the overnight culture, which originated from a colony selected from a plate that was inoculated directly into the broth without enumeration. The number of organisms could also have been influenced by the amount of time allotted for overnight culture incubation. The incubation time was not strictly controlled and a variation of a few minutes or hours could have occurred. The doubling time of E. faecalis has been reported to be approximately 18 min [22]; therefore, a variation of a few minutes or hours could easily account for increased numbers of E. faecalis organisms and, therefore, an increased amount of cytolysin occurring in the filtrate used in the microplate hemolysis assay. Although we did not routinely enumerate the inoculum, we enumerated the overnight E. faecalis-inoculated broth following the overnight incubation period on several occasions and consistently found 108–109 colony forming units (CFUs) per ml. We have not conducted a growth curve for E. faecalis, but reports indicate that the stationary phase of growth occurs between the 12th and 22nd hours of growth [23]. Our overnight cultures would fall within this time range and depending on the initial inoculum, the concentrations of E. faecalis in the overnight cultures could vary. However, other factors affecting cytolysin activity could also be involved.
Twelve E. faecalis isolates from various avian species were used in this study, as shown in Table 1. Using numerous isolates from various species provides evidence that the cytolysin virulence trait may be present in all E. faecalis isolates. By using the microplate hemolysis assay with horse erythrocytes as described above, the authors have demonstrated hemolysis in over 50 E. faecalis isolates, with all isolates tested demonstrating hemolysis. Note that hemolysis, and therefore cytolysin production, was only demonstrated when the E. faecalis isolates were cultured in BHI broth supplemented with 1% glucose and 0.03% L-arginine (BHIGA broth). This is demonstrated in Figure 2 where hemolysis was not observed when E. faecalis was propagated in BHI broth, but hemolysis occurred when propagated in BHIGA broth. This was the most important finding of this study. Cytolysin is a complex molecule encoded by eight genes and is expressed as two molecules, with the smaller molecule involved in quorum signaling [1,10,11,12,14,16]. Maasjost, et al., working with E. faecalis isolates from meat turkeys, were unable to demonstrate hemolysis in ten E. faecalis isolates but were able to demonstrate that seven of the isolates contained cytolysin genes. They deduced that there was no correlation established between genotype and phenotype and “… the lack of phenotypic expression despite genetic evidence indicates the presence of variant (“loss-of-function”) or silent genes that can be activated under in vivo conditions.” [19]. Here, we report the in vitro conditions that allow the expression of E. faecalis cytolysin. The use of BHI broth supplemented with 1% glucose and 0.03% L-arginine was reported by Furumura, et al., using E. faecalis isolates of human origin [24], whereby all isolates that were cultured in BHIGA demonstrated hemolysis; however, none of the isolates cultured in BHI hemolyzed sheep erythrocytes.
The hemolysis results for the filtrate originating from E. faecalis isolate sample 1 using different animal species erythrocytes are displayed in Figure 3. As is clearly demonstrated, horse and sheep erythrocytes are susceptible to hemolysis whereas cow and chicken erythrocytes are less susceptible. We repeated this trial comparing the hemolysis of horse and chicken erythrocytes using 10 additional E. faecalis isolates and even though some isolates displayed a low level of hemolysis with chicken erythrocytes, none equaled or surpassed the level of hemolysis obtained using horse erythrocytes (Figure 4). It has been reported that hemolysis is observed when E. faecalis is cultured on agar prepared with either horse, human, dog, rabbit or mouse erythrocytes but not with sheep, cow or goose erythrocytes [14,17,18]. The report by Myazaki, et al. [18] not only corroborates our finding that horse erythrocytes are more sensitive to hemolysis than cow erythrocytes but it also offers a plausible explanation. The authors noted that the membranes of horse erythrocytes are rich in phosphatidylcholine whereas cow erythrocytes are not. They hypothesized that phosphatidylcholine was needed for membrane binding of the hemolysin. In another study exploring the hemolysin produced by Fusobacterium necrophorum (a Gram-negative bacteria), Amoako, et al. [25] reported that horse erythrocytes were sensitive to the hemolysin produced by Fusobacterium necrophorum, but chicken erythrocytes were insensitive. They also offered evidence that the reason for horse erythrocytes being sensitive was due to the high content of phosphatidylcholine contained in the membranes of horse erythrocytes and concluded that phosphatidylcholine may play a role in the hemolysin receptor mechanism. Here, we have demonstrated, using the microplate hemolysis assay, that sheep erythrocytes are susceptible to hemolysis by E. faecalis but less so than horse erythrocytes (p < 0.001). Following an extensive literature search, the authors believe this is the first report demonstrating that chicken erythrocytes are less sensitive to hemolysis by the E. faecalis cytolysin than erythrocytes from horses or sheep.
5. Conclusions
A 96-well microplate hemolysis assay was developed that proved to be more sensitive for demonstrating hemolysis than culturing on blood agar plates. The incorporation of glucose and L-arginine into BHI culture media was imperative for demonstrating the hemolysin/cytolysin of E. faecalis. Erythrocyte susceptibility to E. faecalis hemolysis was assessed, with horse blood being the most susceptible, followed by sheep blood. Cow and chicken blood were found to be less sensitive to hemolysis by E. faecalis cytolysin. Figure 5 is a graphical abstract of the microplate hemolysis procedure. Because cytolysin is an important E. faecalis virulence trait, the method described here may prove useful in further delineating the role cytolysin plays in the pathogenesis of diseases caused by E. faecalis.
Figure 5.
Pictorial diagram of the procedure for demonstrating the hemolysin/cytolysin of Enterococcus faecalis. (Figure 4 was created using BioRender.com).
Author Contributions
Conceptualization, D.L.R. and M.M.H.; Methodology, D.L.R., M.M.H. and E.B.S.; Validation, M.M.H. and E.B.S.; Statistical Analysis, D.L.R.; Investigation, D.L.R. and E.B.S.; Resources, D.L.R.; Data Curation, E.B.S.; Writing—Original Draft Preparation, D.L.R.; Writing—Review and Editing, M.M.H. and E.B.S.; Supervision, D.L.R.; Project Administration, D.L.R.; Funding Acquisition, D.L.R. and M.M.H. All authors have read and agreed to the published version of the manuscript.
Funding
Support for this project was provided in part by the US Poultry & Egg Association project #F112 and the USDA multistate research project, NC1180.
Institutional Review Board Statement
The study design was approved by the University of Nebraska-Lincoln (UNL) Institutional Animal Care and Use Committee (Project ID 2599, approved on 20 May 2024).
Data Availability Statement
The original contributions presented in this study are included in the article. Further inquiries can be directed to the corresponding author(s).
Conflicts of Interest
The authors declare no conflicts of interest. The funders had no role in the design of the study; in the collection, analyses, or interpretation of data; in the writing of the manuscript; or in the decision to publish the results.
References
- García-Solache, M.; Rice, L.B. The Enterococcus: A Model of Adaptability to Its Environment. Clin. Microbiol. Rev. 2019, 32, 1–28. [Google Scholar] [CrossRef]
- Devriese, L.A.; Hommez, J.; Wijfels, R.; Haesebrouck, F. Composition of the Enterococcal and Streptococcal Intestinal Flora of Poultry. J. Appl. Bacteriol. 1991, 71, 46–50. [Google Scholar] [CrossRef]
- Fertner, M.; Olsen, R.; Bisgaard, M.; Christensen, H. Transmission and genetic diversity of Enterococcus faecalis among layer chickens during hatch. Acta Vet. Scand. 2011, 53, 56. [Google Scholar] [CrossRef]
- Karunarathna, R.; Popowich, S.; Wawryk, M.; Chow-Lockerbie, B.; Ahmed, K.A.; Yu, C.; Liu, M.; Goonewardene, K.; Gunawardana, T.; Kurukulasuriya, S.; et al. Increased Incidence of Enterococcal Infection in Nonviable Broiler Chicken Embryos in Western Canadian Hatcheries as Detected by Matrix-Assisted Laser Desorption/Ionization-Time-of-Flight Mass Spectrometry. Avian Dis. 2017, 61, 472–480. [Google Scholar] [CrossRef]
- Landman, W.J.; Feberwee, A.; Mekkes, D.R.; Veldman, K.T.; Mevius, D.J. A study on the vertical transmission of arthropathic and amyloidogenic Enterococcus faecalis. Avian Pathol. 1999, 28, 559–566. [Google Scholar] [CrossRef]
- Reynolds, D.L.; Loy, J.D. Decrease in Hatchability of Pheasant Eggs Associated with Enterococcus faecalis. Avian Dis. 2020, 64, 517–521. [Google Scholar] [CrossRef] [PubMed]
- Blanco, A.E.; Barz, M.; Icken, W.; Cavero, D.; Mazaheri, A.; Voss, M.; Schmutz, M.; Preisinger, R. Twenty years of amyloid arthropathy research in chickens. World’s Poult. Sci. J. 2016, 72, 495–508. [Google Scholar] [CrossRef]
- Landman, W.J.; Mekkes, D.R.; Chamanza, R.; Doornenbal, P.; Gruys, E. Arthropathic and amyloidogenic Enterococcus faecalis infections in brown layers: A study on infection routes. Avian Pathol. 1999, 28, 545–557. [Google Scholar] [CrossRef] [PubMed]
- Landman, W.J.; vd Bogaard, A.E.; Doornenbal, P.; Tooten, P.C.; Elbers, A.R.; Gruys, E. The role of various agents in chicken amyloid arthropathy. Amyloid 1998, 5, 266–278. [Google Scholar] [CrossRef]
- Coburn, P.S.; Gilmore, M.S. The Enterococcus faecalis cytolysin: A novel toxin active against eukaryotic and prokaryotic cells. Cell Microbiol. 2003, 5, 661–669. [Google Scholar] [CrossRef] [PubMed]
- Fiore, E.; Van Tyne, D.; Gilmore, M.S. Pathogenicity of Enterococci. Microbiol. Spectr. 2019, 7, 1–23. [Google Scholar] [CrossRef]
- Fisher, K.; Phillips, C. The ecology, epidemiology and virulence of Enterococcus. Microbiology 2009, 155, 1749–1757. [Google Scholar] [CrossRef] [PubMed]
- Madsen, K.T.; Skov, M.N.; Gill, S.; Kemp, M. Virulence Factors Associated with Enterococcus Faecalis Infective Endocarditis: A Mini Review. Open Microbiol. J. 2017, 11, 1–11. [Google Scholar] [CrossRef] [PubMed]
- Van Tyne, D.; Martin, M.J.; Gilmore, M.S. Structure, Function, and Biology of the Enterococcus faecalis Cytolysin. Toxins 2013, 5, 895–911. [Google Scholar] [CrossRef] [PubMed]
- Murase, K. Cytolysin A (ClyA): A Bacterial Virulence Factor with Potential Applications in Nanopore Technology, Vaccine Development, and Tumor Therapy. Toxins 2022, 14, 78. [Google Scholar] [CrossRef] [PubMed]
- Gaspar, F.B.; Crespo, M.T.B.; Lopes, M.F.S. Proposal for a reliable enterococcal cytolysin production assay avoiding apparent incongruence between phenotype and genotype. J. Med. Microbiol. 2009, 58, 1122–1124. [Google Scholar] [CrossRef] [PubMed]
- Libertin, C.R.; Dumitru, R.; Stein, D.S. The hemolysin/bacteriocin produced by enterococci is a marker of pathogenicity. Diagn. Microbiol. Infect. Dis. 1992, 15, 115–120. [Google Scholar] [CrossRef] [PubMed]
- Miyazaki, S.; Ohno, A.; Kobayashi, I.; Uji, T.; Yamaguchi, K.; Goto, S. Cytotoxic effect of hemolytic culture supernatant from Enterococcus faecalis on mouse polymorphonuclear neutrophils and macrophages. Microbiol. Immunol. 1993, 37, 265–270. [Google Scholar] [CrossRef]
- Maasjost, J.; Lüschow, D.; Kleine, A.; Hafez, H.M.; Mühldorfer, K.; Bondi, M. Presence of Virulence Genes in Enterococcus Species Isolated from Meat Turkeys in Germany Does Not Correlate with Chicken Embryo Lethality. BioMed Res. Int. 2019, 2019, 6147695. [Google Scholar] [CrossRef]
- Stępień-Pyśniak, D.; Hauschild, T.; Dec, M.; Marek, A.; Urban-Chmiel, R.; Kosikowska, U. Phenotypic and genotypic characterization of Enterococcus spp. from yolk sac infections in broiler chicks with a focus on virulence factors. Poult. Sci. 2021, 100, 100985. [Google Scholar] [CrossRef] [PubMed]
- Sæbø, I.P.; Bjørås, M.; Franzyk, H.; Helgesen, E.; Booth, J.A. Optimization of the Hemolysis Assay for the Assessment of Cytotoxicity. Int. J. Mol. Sci. 2023, 24, 2914. [Google Scholar] [CrossRef] [PubMed]
- Deenadayalan, K.G.; Meganathan, Y.; Sivaramakrishnan, M.; Ko, R.; Muthusamy, A.; Seviour, T.; Kandaswamy, K. Enterococcus faecalis thrives in dual-species biofilm models under iron-rich conditions. Arch. Microbiol. 2022, 204, 710. [Google Scholar] [CrossRef]
- Lontsi Djimeli, C.; Antoine, T.; Rossi, V.; Nina, N.; Vincent, R.; Bricheux, G.; Nola, M.; Sime-Ngando, T. Impact of two disinfectants on detachment of Enterococcus faecalis from polythene in aquatic microcosm. Res. Biotechnol. 2016, 7, 28–42. [Google Scholar]
- Furumura, M.T.; Figueiredo, P.M.S.; Carbonell, G.V.; Darini, A.L.D.; Yano, T. Virulence-associated characteristics of strains isolated from clinical sources. Braz. J. Microbiol. 2006, 37, 230–236. [Google Scholar] [CrossRef]
- Amoako, K.K.; Goto, Y.; Misawa, N.; Xu, D.L.; Shinjo, T. The erythrocyte receptor for Fusobacterium necrophorum hemolysin: Phosphatidylcholine as a possible candidate. FEMS Microbiol. Lett. 1998, 168, 65–70. [Google Scholar] [CrossRef]
Disclaimer/Publisher’s Note: The statements, opinions and data contained in all publications are solely those of the individual author(s) and contributor(s) and not of MDPI and/or the editor(s). MDPI and/or the editor(s) disclaim responsibility for any injury to people or property resulting from any ideas, methods, instructions or products referred to in the content. |
© 2025 by the authors. Licensee MDPI, Basel, Switzerland. This article is an open access article distributed under the terms and conditions of the Creative Commons Attribution (CC BY) license (https://creativecommons.org/licenses/by/4.0/).